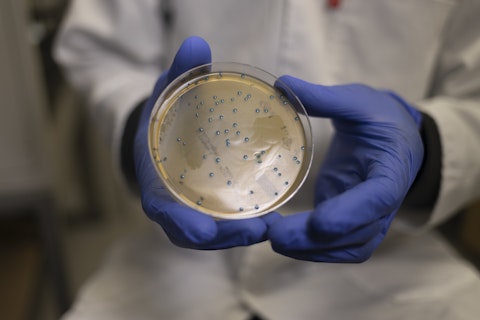
Scientist with Petri Dish

Filtrer par Type
Filtrer par Date
Sujet
567 résultats trouvés

Côte d’Ivoire : nouvelles exigences d’étiquetage dans le cadre du Programme de Conformité des Produits (PCA CI71)
La Côte d’Ivoire a récemment introduit d’importantes mises à jour dans le cadre de son Programme de Conformité des Produits (PCA CI71), qui s’applique aux importations de biens soumis à évaluation de conformité avant leur entrée sur le territoire. Ces évolutions concernent principalement les exigences d’étiquetage et de marquage des produits, et visent à garantir une information plus claire, accessible et conforme pour les consommateurs, les distributeurs et les autorités locales.
En savoir plus
SGS IDEA Lab obtient l’accréditation ISO 17025 : un nouveau standard pour les analyses microbiologiques
SGS IDEA Lab est désormais accrédité ISO 17025 par le Cofrac pour ses analyses microbiologiques. Une garantie de fiabilité, de conformité réglementaire et d’accès aux marchés internationaux pour les secteurs cosmétique, pharmaceutique et bio-actifs.
En savoir plus
Comprendre la mise à jour de la réglementation des cosmétiques en Arabie saoudite
Découvrez comment notre expertise approuvée par la SFDA aide les marques de cosmétiques à naviguer avec confiance dans l’évolution du paysage réglementaire de l’Arabie Saoudite.
En savoir plus
Polluant du bâtiment : dépolluer et réhabiliter les sites industriels
Un enjeu majeur pour la réindustrialisation de la France et la transition écologique.
En savoir plus
SGS créé un Groupement Momentané d’Entreprises avec ses partenaires pour former les équipes d’EDF en soudage et contrôles non destructifs
Une nouvelle étape qui témoigne de la reconnaissance du savoir-faire de SGS au cœur des grands projets industriels d’EDF
En savoir plus
Plus de 800 millions d’appareils EE en Europe d’ici 2030 : SGS accompagne la vérification tierce partie pour garantir réparabilité et durabilité
SGS se positionne comme acteur essentiel de la conformité et de la fiabilité des calculs réglementaires afin d’accompagner fabricants, importateurs et distributeurs vers des produits plus responsables.
En savoir plus
Tests solaires in vitro & in vivo : SGS accompagne les marques avec la nouvelle norme ISO 23675
SGS propose une offre complète de tests solaires in vitro et in vivo, incluant la nouvelle méthode ISO 23675, pour garantir performance, sécurité et conformité réglementaire.
En savoir plus
SGS élargit son offre de solutions carbone grâce à l’acquisition de Sami
Sami est une startup française basée à Paris, qui propose une plateforme tout-en-un de pilotage climatique et de comptabilité carbone.
En savoir plus
SGS ICS, nouvel organisme habilité à auditer le label PME+
Depuis septembre 2025 SGS ICS, organisme évaluateur indépendant reconnu dans les domaines des audits, certifications et labellisations, est officiellement habilité par la Fédération des Entreprises et Entrepreneurs de France (FEEF) pour conduire les audits menant à la labellisation PME+.
En savoir plus
Partenariat : SGS s’associe à Forindustrie pour promouvoir les métiers de l’industrie
SGS est fier d’être partenaire de Forindustrie pour accompagner cette aventure humaine et technologique qui met en lumière les acteurs, les savoir-faire et les innovations du secteur industriel.
En savoir plus